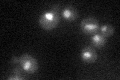
YDR301W

View description
RNA-binding subunit of the mRNA cleavage and polyadenylation factor; involved in poly(A) site recognition and required for both pre-mRNA cleavage and polyadenylation, 51% sequence similarity with mammalian AAUAA-binding subunit of CPSF
Localization:
Intensity:
Fold change:
Significance:
-
C’ GFP library in SD
nucleus27.95 -
N' NOP1pr-GFP in SD

N/A0 -
N' TEF2pr-mCherry in SD

N/A0 -
N' NATIVEpr-GFP in SD

N/A0 -
N' TEF2pr-VC and Cyto-VN in SD

N/A0 -
C’ GFP library in SD+DTT

nucleus23.540.84No -
C’ GFP library in SD+H2O2

nucleus31.61.13No -
C’ GFP library in Starvation Media

nucleus23.820.85No -
C’ GFP library on the background of Pup2-DaMP

nucleus -
C’ GFP library on the background of CCT mutant

nucleus30.67051.09698No
